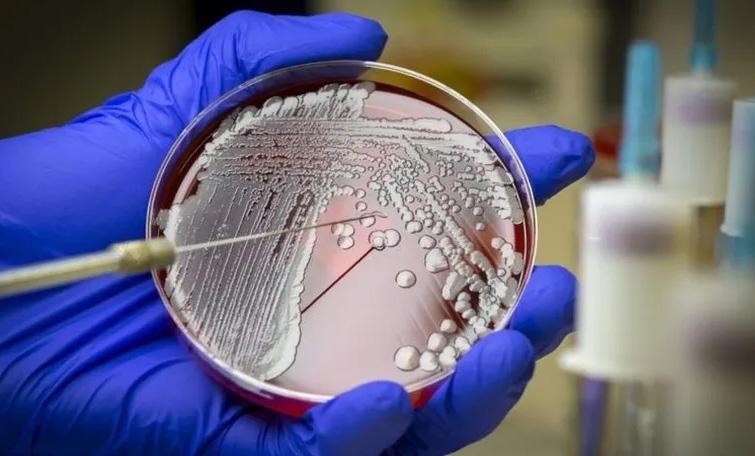

Fundado em 26 de fevereiro de 1991
Fundado em 26 de fevereiro de 1991



Rio de Janeiro, Terça-feira, 30 de Maio de 2023


 Fundado em 26 de fevereiro de 1991
Fundado em 26 de fevereiro de 1991



Rio de Janeiro, Terça-feira, 30 de Maio de 2023
A Polícia Civil prendeu, durante operação na manhã de segunda-feira (29), 33 suspeitos de participar de uma organização criminosa que aplicou o golpe dos nudes em 12 estados brasileiros. As prisões ocorreram em 11 cidades do Rio Grande do Sul e de Santa Catarina (saiba quais abaixo). Segundo a polícia, sete deles já estavam em cadeias. Pág. 4

Operação do 25º BPM apreende diversos veículos sem placa em Armação dos Búzios Pág. 4


O presidente Luiz Inácio Lula da Silva defendeu na segunda-feira (29) a união de países latino-americanos durante entrevista coletiva de imprensa ao lado do presidente da Venezuela, Nicolás Maduro.

“A América do Sul precisa trabalhar como bloco. Não dá pra imaginar que, sozinho, um país vai resolver os seus graves problemas que já perduram mais de 500 anos”, defendeu o presidente brasileiro. Pág. 3

Rio das Ostras prossegue com as Audiências Públicas que possibilitam aos moradores indicar prioridades de investimentos públicos para 2024. As reuniões são promovidas pela Prefeitura, por intermédio da Secretaria de Gestão Pública, e o Conselho Municipal de Planejamento e Orçamento Participativo – CMPOP. Pág. 8

Mutirão de histeroscopia no Hospital Municipal Rodolpho Perissé em búzios
A Prefeitura de Armação dos Búzios, na Região dos Lagos do Rio, por meio da Secretaria Municipal de Saúde, realizou um bem-sucedido mutirão de histeroscopia ou videohisteroscopia no Hospital Municipal Rodolpho Perissé (HMRP). O objetivo dessa iniciativa foi eliminar a fila de espera para esse importante exame ginecológico. Pág. 2

A Prefeitura de Armação dos Búzios, na Região dos Lagos do Rio, por meio da Secretaria Municipal de Saúde, realizou um bem-sucedido mutirão de histeroscopia ou videohisteroscopia no sábado (27), Hospital Municipal Rodolpho Perissé (HMRP). O objetivo dessa iniciativa foi eliminar a fila de espera para esse importante exame ginecológico.

A ação foi planejada para agilizar o atendimento e garantir que as pacientes tivessem acesso a esse procedimento, colocando um fim à fila de espera que existia na secretaria de saúde. Com isso, as pacientes que aguardavam pelo exame puderam desfrutar de um atendimento ágil e eficiente.
A histeroscopia é um procedimento minimamente invasivo no qual uma câmera de pequeno calibre é inserida na vagina, permitindo a exploração das partes internas do útero e do colo uterino. Essa técnica é usada tanto para fins diagnósticos quanto cirúrgicos.
Segundo a diretora do HMRP, Priscila Gasparetto, na modalidade cirúrgica, é possível tratar tumores benignos, remover pólipos uterinos, tratar sinéquias, corrigir o septo ute-
rino e realizar a ablação do endométrio para o tratamento de sangramentos benignos anormais. A Prefeitura de Búzios reafirma seu compromisso
em garantir a saúde e o bem-estar da população, buscando soluções para reduzir as demandas reprimidas na área da saúde. O mutirão de histerosco-
pia é mais uma iniciativa do governo municipal para otimizar o acesso aos serviços de saúde e assegurar um atendimento de qualidade.
A Secretaria de Segurança e Ordem Pública, por meio da coordenadoria da Defesa Civil alerta a população para o primeiro caso positivo de vírus H5N1 em uma ave silvestre encontrada no bairro Santo Antônio, em Cabo Frio, pelos profissionais do Centro de Reabilitação de Aves Silvestres.
O animal foi encaminhado para empresa de gestão ambiental, a Ambipar, localizada em Araruama, onde foram realizados os testes de diagnóstico da doença. O Centro de Informações Estratégicas em Vigilância em Saúde (CIEVS) da Secretaria Estadual de Saúde (SES-RJ) já foi notificado e a ocorrência registrada ao Ministério da Saúde.
A Defesa Civil informa que em Búzios não foi registrado nenhum caso até o momento e orienta para que a população não recolha as aves que encontrarem doentes ou mortas e acione a Defesa Civil ou Guarda Marítima Ambiental, através dos telefones: (22) 99824-9377 ou 99920-2872
Técnicos da Vigilância em Saúde da Secretaria Estadual ressaltam que não há motivos de preocupação para a população sobre epidemia de H5N1, pois no momento não há
Semestre termina sem pagamento adicional na tarifa; Aneel estima que este cenário pode durar até o fim de 2023
O consumidor terá bandeira tarifária verde na conta de luz no mês de junho, o que significa que não haverá complemento de cobrança na tarifa. O anúncio foi feito pela Agência Nacional de Energia Elétrica (Aneel) na sexta-feira (26). Com este anúncio, os consumidores completaram o primeiro semestre do ano sem a cobrança do adicional, cenário que permanece inalterado desde abril de 2022.
A bandeira verde sinaliza condições favoráveis de geração de energia. Ela é válida para todos os consumidores conectados ao Sistema Interligado Nacional — a malha de transmissão de energia que cobre quase todo o território brasileiro e conecta as usinas aos con-
sumidores. Segundo estimativa da Aneel, é provável que a bandeira verde permaneça durante todo este ano. Ela reflete a melhoria dos níveis dos reservatórios das hidrelétricas, que foram beneficiados com o período de chuvas. O nível de armazenamento dos reservatórios atingiu 87% em média no início do período seco. Com isso, há condições favoráveis para a produção de energia no país. As bandeiras verde, amarela ou vermelha, que incidem na tarifa, indicam se a energia custará mais ou menos em função das condições de geração de eletricidade. O sistema, implantado em 2015, é uma forma de apresentar um custo que já estava na conta de energia, mas que geralmente passava despercebido aos consumidores. O mecanismo trouxe mais transparência aos valores cobrados.
Feira dos Povos Tradicionais de Búzios será realizada neste fim de semana em frente à Praça Santos Dumont
transmissão direta, de pessoa para pessoa.
É importante ressaltar que a doença não é transmitida pelo consumo de carne de aves e nem de ovos. As infecções humanas pelo vírus da Influenza Aviária ocorrem por meio do contato direto com aves infectadas (vivas ou mortas).
O ministro da Agricultura e Pecuária, Carlos Fávaro, declarou estado de emergência zoossanitária por 180 em todo o território nacional em função da detecção da infecção pelo vírus da influenza aviária de alta patogenicidade (IAAP)H5N1 - em aves silvestres no Brasil. A medida foi publicada na edição extra do Diário Oficial da União desta segunda-feira (22), na Portaria nº 587.
SOBRE A H5N1

A H5N1 ou Influenza Aviária é uma doença causada por vírus, que afeta muitas espécies de aves, inclusive migratórias; e, eventualmente, mamíferos terrestres e marítimos, suínos e o próprio ser humano. Sua incidência gera graves consequências à saúde animal, à economia e ao meio ambiente.
O Hotel da Cachoeira fica localizado na Colônia Finlandesa do Penedo-RJ, um destino turístico pitoresco que ainda preserva características de sua colonização escandinava. Fica entre Rio e São Paulo, aos pés das Agulhas Negras, nos limites do Parque Nacional de Itatiaia.


Penedo é um precioso santuário ecológico, privilegiado pelo clima de montanha e sua natureza exuberante! Possui Mata Atlântica remanescente, que abriga espécies de animais e vegetais que só existem nela, além de diversas cachoeiras. Cenário perfeito para um passeio romântico em busca de paz, sossego e tranquilidade ou fazer caminhadas ecológicas, trilhas e até escaladas. Penedo também possui uma vida noturna agitada com uma variedade de bares e restaurante.
A arquitetura do hotel respeita o relevo montanhoso da região. Sendo assim, temos escadas para o acesso ao café da manhã e chalés.
EXPEDIENTE
Fundado em 26/02/91

O Franco Grafica e Editora Ltda - ME
CNPJ nº 26.753.088/0001-06
Insc. Munic. 1/0038107 // Insc. Estadual 87.295.559

Presidente: Aloisio Santiago Monteiro
Editoração e impressão: O Franco Grafica e Editora Ltda - ME
Periodicidade: Diário /// Tiragem: 30.000

Redação: Endereço: Rua Casimiro de Abreu, 189
Centro, Cabo Frio - RJ, CEP: 28905-360
E-mail: tribunadosmunicipios@gmail.com
Comercial: (22) 992122715 / Telefone (22) 20411787
Região Metropolitana Belford Roxo; Duque de Caxias; Guapimirim; Itaboraí; Itaguaí; Japeri; Magé; Mesquita; Nilópolis; Niterói; Nova Iguaçu; Paracambi; Queimados; São Gonçalo; São João de Meriti; Seropédica;Tanguá e Assembleia Legislativa do Rio de Janeiro (Alerj).
Norte e Noroeste Fluminense
Aperibé; Bom Jesus do Itabapoana; Cambuci; Italva; Itaocara; Itaperuna; Laje do Muriaé; Miracema; Natividade; Porciúncula; Santo Antônio de Pádua; São José de Ubá; VarreSai; Campos dos Goytacazes; Carapebus; Cardoso Moreira; Conceição de Macabu; Macaé Quissamã; São Fidélis; São Francisco de Itabapoana e São João da Barra.
A Secretaria de Cultura e Patrimônio Histórico de Armação dos Búzios realizará nos dias 02 e 03 de junho, a Feira dos Povos Tradicionais, no pátio da secretaria em frente à Praça Santos Dumont, no Centro, a partir das 15h. Atrações culturais, rodas de conversas, contação de histórias, artesanatos, comidas típicas, entre outros farão parte da feira.
Programação:
- Sexta-feira (02)
15h – Abertura
16h – Contação de História (Prof.ª Taísa) – Toca do Boi
19h – Desfile das Caiçaras (participação de Leny Morais)
- Sábado (03)
15h – Abertura
16h – Roda de Conversa (133 anos da Lei Áurea)
19h – Quilombo da Baía Formosa (Dona Cássia)
20h – Mulheres Jongueiras da Rasa
Região dos Lagos Araruama; Armação dos Búzios; Arraial do Cabo; Cabo Frio; Cachoeiras de Macacu; Casimiro de Abreu; Iguaba Grande; Maricá; Rio Bonito; Rio das Ostras; São Pedro da Aldeia; Saquarema e Silva Jardim.
Médio Paraíba Barra do Piraí; Barra Mansa; Itatiaia; Pinheiral; Piraí; Porto Real; Quatis; Resende; Rio Claro; Rio das Flores; Valença e Volta Redonda. Região Centro-Sul Fluminense Areal; Comendador Levy Gasparian; Engenheiro Paulo de Frontin; Mendes; Miguel Pereira; Paraíba do Sul; Paty do Alferes; Sapucaia; Três Rios; Vassouras; Angra dos Reis; Mangaratiba e Paraty.

O presidente Luiz Inácio Lula da Silva defendeu na segunda-feira (29) a união de países latino-americanos durante entrevista coletiva de imprensa ao lado do presidente da Venezuela, Nicolás Maduro.

“A América do Sul precisa trabalhar como bloco. Não dá pra imaginar que, sozinho, um país vai resolver os seus graves problemas que já perduram mais de 500 anos”, defendeu o presidente brasileiro.
“Se a gente estiver junto, nós temos 450 milhões de pessoas, a gente tem um PIB de quase US$ 4,5 trilhões. A gente tem força no processo de negociação e é por isso que esse momento [cúpula] é importante”, completou.
Cúpula
A partir de terça-feira (30), chefes de Estado de países da América do Sul se reúnem em Brasília,
no Palácio Itamaraty. Os presidentes de Argentina, Bolívia, Chile, Colômbia, Equador, Guiana, Para-
guai, Suriname, Uruguai e Venezuela confirmaram presença. Um encontro desse porte não ocor-
re há, pelo menos, sete anos. “O principal objetivo desse encontro é retomar
o diálogo com os países sul-americanos, que ficou muito truncado nos últimos anos, e é uma prio-
ridade do governo Lula. Temos consciência que há diferença de visão e diferenças ideológicas entre os países, mas ele [Lula] quer reativar esse diálogo a partir de denominadores comuns com os países”, explicou a embaixadora Gisela Padovan, secretária de América Latina e Caribe do Ministério das Relações Exteriores (MRE), na última sexta-feira (26).
Embora o governo brasileiro evite apontar uma proposta específica, há a expectativa de que os presidentes discutam formas mais concretas de ampliar a integração, incluindo a possibilidade de criação ou reestruturação de um mecanismo sul-americano de cooperação, que reúna todas as nações da região. Atualmente, não existe nenhum bloco com essas características.
Fonte: Agência Brasil




Parceria põe o Rio à frente da pauta da transição ecológica e colabora com o objetivo de se tornar a Capital Verde da América
O Governo do Estado do Rio de Janeiro e a TotalEnergies assinaram, na sexta-feira (26), o Memorando de Entendimentos (MoU, na sigla em inglês) uma atuação em conjunto para o desenvolvimento da geração eólica offshore no estado. O acordo, com duração de dois anos, marca a colaboração entre o estado e a empresa nos estudos relacionados aos incentivos fiscais, tributários e à expansão para futuros projetos.

Ao assinar o documento, o governador Cláudio Castro manifestou a sua satisfação pelo avanço de ações sustentáveis no Rio de Janeiro, o que classificou como uma vocação. O acordo foi celebrado com Charles Fernandes, diretor-geral da empresa TotalEnergies EP Brasil e presidente da marca no país. Participou também o secretário de Estado de Energia e Economia do Mar, Hugo Leal. - É uma honra a assinatura deste memorando. É mais uma importante conquista para o conjunto de ações que estamos realizando nos últimos anos para recuperar o protagonismo do Estado do Rio de Janeiro, especialmente na pauta da transição ecológica. O Rio tem vocação energética, um hub do Brasil e o nosso objetivo é transformar o nosso estado na Capital Verde da América Latina – declarou o governa-

Visando desenvolver energia eólica no Rio, Cláudio Castro assina Memorando de Entendimentos com a TotalEnergies
dor Cláudio Castro.
Energia eólica
O secretário Hugo Leal destacou as vantagens competitivas do Rio de Janeiro para a implantação de usinas eólicas offshore.
- O Estado do Rio de Janeiro, além dos ventos constantes na região Norte Fluminense, tem como
diferencial a infraestrutura logística e portuária adequada para a implantação de eólicas offshore. Temos portos localizados estrategicamente que facilitam o transporte das turbinas, torres e todos os componentes das usinas eólicas da terra para o mar. Além disso, temos mais de 40 anos de experiência em atividades offshore, adquiridas com a
exploração de petróleo nas águas profundas, mão de obra qualificada e empresas especializadas no segmento offshore - afirmou.
No Brasil há quase 50 anos, a TotalEnergies avalia áreas desde o ano passado para licenciamento ambiental de projetos eólicos offshore. No final de 2022, a empresa anunciou a assinatura de um MoU com Prumo
Logística, holding controlada pelo EIG e responsável pelo desenvolvimento do Porto do Açu, para estudos que visam a instalação de bases de apoio logístico no Açu para apoiar projetos eólicos que venham a ser desenvolvidos pela TotalEnergies.
- Estamos entusiasmados com esta parceria com o Governo porque reforça
a sinergia da TotalEnergies com o movimento de expansão do mercado das eólicas offshore. A Companhia tem reconhecida experiência no segmento. A assinatura está alinhada com a nossa estratégia de alcançar a neutralidade de carbono até 2050 e com o nosso compromisso de investir a longo prazo no país - afirma Charles Fernandes, Diretor Geral da TotalEnergies EP Brasil e Country Chair da Companhia no Brasil.
A TotalEnergies opera no Brasil há quase 50 anos, através de seis subsidiárias, e hoje emprega mais de 3.500 pessoas em seus segmentos de negócios, em atividades de exploração e produção, gás, energias renováveis (solar e eólica), lubrificantes, produtos químicos e distribuição.
O portfólio de Exploração & Produção da empresa inclui atualmente dez licenças, das quais quatro são de ativos operados. Adicionalmente, a TotalEnergies arrematou, em dezembro de 2022, um novo bloco não-operado de exploração em águas profundas, na bacia de Campos (Água Marinha, 30%), cujo Contrato de Partilha de Produção deverá ser assinado no primeiro semestre de 2023. Em 2022, a produção média da empresa no país foi de 104 mil barris de óleo equivalente por dia.
Marcelo Camargo/Agência Brasil
Foram cumpridos 41 mandados de prisão em 11 cidades do Rio Grande do Sul e de Santa Catarina na manhã desta segunda feira (29).
A Polícia Civil prendeu, durante operação na manhã de segunda-feira (29), 33 suspeitos de participar de uma organização criminosa que aplicou o golpe dos nudes em 12 estados brasileiros. As prisões ocorreram em 11 cidades do Rio Grande do Sul e de Santa Catarina (saiba quais abaixo). Segundo a polícia, sete deles já estavam em cadeias.

O esquema foi tema do programa Linha Direta, da Rede Globo, na última quinta-feira (25). O golpe tinha como alvos homens que eram atraídos nas redes sociais por mulheres, com as vítimas trocavam fotos íntimas. Em seguida, uma suposta terceira pessoa entrava na conversa e dizia que a mulher era, na verdade, uma menor de idade, e começava a cobrar dinheiro para que o homem não tivesse suas fotos expostas.
No Rio Grande do Sul, as prisões desta segunda aconteceram em: Porto Alegre, Canoas, Cachoeirinha, Gravataí, Alvorada, Viamão, Tramandaí e Imbé. Em Santa Catarina, as ações foram em: Florianópolis, Ingleses e Carianos.
Foram cumpridos 11 mandados de prisão preventiva; 30 de prisão temporária; 33 de busca e apreensão; e 25 bloqueios de contas bancárias.
Desde o começo da investigação policial, há quase um ano, pelo menos 140 pessoas foram presas só no Rio Grande do Sul. Os suspeitos atraiam empresários, médicos e até políticos. A investigação identificou 80 vítimas do golpe em todo o país. Só uma delas teria perdido mais de R$ 100 mil. O prejuízo total chega a R$ 5 milhões.
Pessoas que sofreram o golpe foram identificadas nos seguintes estados: Amazonas, Bahia, Espírito Santo, Goiás, Minas Gerais, Mato Grosso do Sul, Pará,
Vítimas atraídas nas redes sociais
O crime consiste na extorsão de usuários de redes sociais, geralmente homens mais velhos, após o envio de fotos íntimas, na maioria das vezes por jovens mulheres. Depois da troca de mensagens, um suposto parente ou autoridade policial entra em contato dizendo que a jovem era, na verdade, menor de idade. Os golpistas, então, tentam extorquir dinhei-


ro das vítimas para que elas não sejam expostas.
Os criminosos chegavam a montar cenários para simular delegacias e filmar a encenação do momento em que seria feito o registro da ocorrência por pedofilia contra as vítimas de estelionato. Delegacias falsas da Polícia Civil foram descobertas em Novo Hamburgo, na Região Metropolitana de Porto Alegre.
A Polícia Civil descobriu, ainda, que uma adolescente de 17 anos foi aliciada pela organização criminosa. Ela se fotografava, recebia entre R$ 100 e R$ 200 por “pacote
de imagens” e as fotografias eram usadas no esquema
Há suspeita do aliciamento de outras adolescentes e também de jovens de 18 ou 19 anos que se passavam por menores de idade.
A organização criminosa é suspeita dos crimes de extorsão, corrupção de menores, tráfico de drogas, lavagem de dinheiro e porte ilegal de arma de fogo.
As cidades em que ocorre a operação
• Florianópolis
• São Cristóvão do Sul
• Porto Alegre
• Sapucaia do Sul
• Tramandaí
• Santa Vitória do Palmar
• Gravataí
• Viamão
• Cachoeirinha
• Joinville
• Canoas
Como denunciar
A Polícia Civil destaca que nenhum policial liga ou manda mensagens para a exigência de qualquer tipo de valor, para negociar cumprimento de mandados ou deixar de cumprir mandados de prisão. Caso esse tipo de situação aconteça, é orientado que seja feito o registro de um boletim de ocorrência em uma delegacia.
• Disque denúncia –08005102828
• WhatsApp e Telegram(51) 9 8444-0606
Conversas obtidas pela polícia entre os estelionatários e uma vítima do golpe
No final de semana, cerca de 20 motocicletas foram apreendidas em uma operação do 25º Batalhão da Polícia Militar, sob o comando do Tenente-Coronel Oliveira. As ações acontecem em cumprimento à Lei Federal 14.562/2023, que criminaliza a conduta de quem adultera sinal identificador de veículo não categorizado como automotor.

O Prefeito Alexandre Martins, como chefe do Poder Executivo Municipal, parabeniza o comando do 25º BPM e as equipes envolvidas na missão de garantir a ordem e a paz, não apenas a Búzios, mas a toda Região dos Lagos, por meio das ações de combate à desordem e ao crime.
Em breve, o município de Búzios concluirá as obras de estruturação e documentação para o funcionamento do Depósito Público, para onde serão enviados os veículos irre -
gulares que forem flagrados circulando pela cidade, melhorando o ordenamento no trânsito de Búzios. Desde a aprovação da
Lei Federal 14.562/2023, o 25º BPM, tem realizado diversas operações com o intuito de garantir mais segurança aos moradores e
turistas de Búzios, uma vez que a maior parte dos roubos de rua são praticados por criminosos em motos sem qualquer identificação.
1 - Transitando em Parada de Lucas com um carro roubado, na noite de ontem, “Chem” e comparsa foram presos durante uma ação do BPChq. A dupla foi encaminhada à 38ª DP.

2 - Apontado como gerente do tráfico das Casinhas do Nolita (Campos dos Goytacazes), “Tato” é preso durante ação do 8º BPM que apreendeu, no domingo (28), armas, munições, rádio comunicador e balança de precisão. A ação teve apoio da 146ª DP.

3 - Traficantes de drogas atacam policiais do 14º BPM em Bangu, na comunidade do Santo André. Houve confronto e dois criminosos acabaram morrendo. Com eles, um fuzil, uma pistola, uma granada, munições, um rádio transmissor e farto material entorpecente foram apreendidos.


4 - Após um forte ataque armado contra policiais do 20º BPM em um dos acessos à comunidade do Campo Belo, localizada no bairro da Lagoinha, em Nova Iguaçu, foi feito um cerco tático e dois homens portanto um fuzil, uma pistola, uma granada e dois rádios transmissores foram presos.
5 - Um homem com um veículo roubado atacou a tiros policiais militares do 12º BPM na Rua Prefeito Ivan Mundin, no bairro do Boqueirão, em Maricá. O criminoso foi preso, o carro foi recuperado e uma arma de fogo e munições foram apreendidas. A ocorrência está em andamento.

A Biblioteca Municipal

Professora Íris Galvão, em parceria com o Projeto
Biblioteca à Mostra, do Polo Universitário de Rio das Ostras da Universidade Federal Fluminense, apresenta a exposição
“EmpoderArte: O poder da Mulher na Arte”.
Além de obras de mulheres da região, a exposição apresenta mulheres que desafiaram padrões, romperam barreiras, inspiraram gerações e fizeram história na arte e cultura brasileira.
A exposição serve também para refletir sobre a importância da igualdade de gênero e a valorização das mulheres na sociedade.
Os visitantes vão poder conhecer um pouco sobre a personalidades como Madalena Caramuru, Dandara, Chiquinha Gonzaga, Cora
Coralina, Anita Garibaldi, Clarice Lispector, Carolina
Maria de Jesus, Sônia Guajajara, Bárbara de Alencar, Antonieta de Barros, Carmen Miranda e muitas outras.
A exposição “EmpoderArte: O poder da Mulher na Arte” é uma oportunidade
de se conectar com a arte e conhecer mais sobre essas mulheres incríveis que revolucionaram o Brasil.
O horário de visitação é o mesmo de funcionamento da Biblioteca, de segunda a sexta, das 9h às 18h. A unidade fica na Avenida amazonas, s/n, no Centro.
A exposição está no hall de entrada da biblioteca
O projeto Biblioteca à Mostra apresenta um conjunto de atividades artísticas e culturais realizadas no espaço da Biblioteca Municipal e do Campus da UFF Rio das Ostras, buscando como foco o diálogo entre a Biblioteca, a Universidade e a produção cultural da região.
Munícipes também puderam realizar perguntas sobre o tema em questão.

HOMENAGEM – Na ocasião, diante de perdas de servidores da Saúde, todos os presentes fizeram um minuto de silêncio para homenagear os trabalhadores:
Alberto Lessa, gastroenterologista; Rones de Oliveira Veloso, enfermeiro; Marcio Goltarios Magalhães, fiscal sanitário e Francisco Antônio Sobral Júnior, motorista, falecidos nos últimos meses.
Para o secretário de saúde, Denilson Santa Rosa, a prestação de contas é uma obrigação legal e de suma importância para demonstração da aplicação dos recursos públicos destinados para cada área.
No domingo (28), foi realizada a décima Copa Erli, que marcou a volta do Marreta ao triunfo.
Uma competição muito equilibrada, que ficou marcada pela qualidade técnica de alguns jogadores, que acabaram por fazer a diferença para o título.
A final foi entre Marreta e Meia Boca, e o placar final foi de 4x1 para o Marreta, que merecidamente pode gritar campeão de novo.
O Marreta irá distribuir uma cesta básica para uma família necessitada, entregue pelo nosso amigo @thiagovasconcelosoficial.
Obrigado aos patrocinadores e atletas, mês que vem tem mais.
Meia Boca Juniors -
Sport Club Invictus -
Marreta Futebol ClubeSalseiro Futebol Clube -

Real Madruga -
MPRJ ajuíza ação para que Hotel Urbano cumpra novas vendas e faça reembolso imediato aos consumidores que tiveram seus pacotes cancelados
O Ministério Público do Estado do Rio de Janeiro (MPRJ), por meio da 3ª Promotoria de Justiça de Tutela Coletiva de Defesa do Consumidor e do Contribuinte da Capital, ajuizou em dezembro de 2022, ação civil pública em face do Hotel Urbano (HURB), em razão do não cumprimento com o ofertado, devido aos constantes cancelamentos e adiamentos das datas fixadas dos pacotes turísticos que comercializa no mercado de consumo. Aponta o MPRJ que, a partir das inúmeras reclamações contra a agência de viagens digital, há provas mais do que suficientes de que o atuar do réu vem causando inúmeros danos, tanto de ordem material, quanto moral, em razão das práticas irregulares e atentatórias aos direitos dos consumidores, tais como publicidade e venda enganosa, oferta não cumprida e serviço não fornecido.
Na ACP, o Ministério Público fluminense requer que a Justiça determine que o HURB realize imediatamente o reembolso dos valores pagos pelos consumidores que adquiriram pacotes turísticos até a entrada em vigor da medida provisória nº 948/20, de 08 de abril de 2020, na forma do art. 35, III da lei nº 8.078/90, se assim o desejarem, monetariamente atualizados, sob pena de pagamento de R$ 50 mil de multa por ocorrência; realize imediatamente o reembolso dos valores pagos pelos consumidores que adquiriram pacotes turísticos entre 31/12/2020 e 15/07/2021 (inclusive), na forma do disposto na redação original do § 6º, art. 2º da lei nº 14.046/20, uma vez que o prazo para tanto era até o dia 31/12/2021, já que o prazo para reembolso era de doze meses após cessado o período de calamidade pública decorrente da pandemia de COVID-19, conforme determinado no Decreto Legislativo nº 06, o que cessou em 31/12/2020, caso o cancelamento do serviço turístico correlato tenha se dado por conta de tal estado calamitoso.
Todos os municípios são obrigados por lei a apresentar quadrimestralmente o desempenho orçamentário Mais transparência para os investimentos em saúde.
A Administração Municipal de Rio das Ostras reali-
zou na sexta-feira (26), na Câmara dos Vereadores, a prestação de contas do primeiro quadrimestre de 2023, que tem como objetivo apresentar para a população tudo que foi feito e também avaliar o cumprimento das metas estabelecidas para o
período.
A realização da apresentação é uma exigência feita por lei, que obriga a todos os municípios a apresentar quadrimestralmente ao poder legislativo e à população, o desempenho orçamentário da Secretaria de Saúde.
“A prestação de contas é de suma importância, onde são apresentados os indicadores, pontuando os serviços ofertados à população. A Secretaria de Saúde tem se esforçado bastante para amenizar os impactos decorrentes da Covid-19 e o planejamento para os próximos quadrimestres”, destacou.
O Banco de Empregos, unidade da Secretaria de Desenvolvimento Econômico e Turismo da Prefeitura de Rio das Ostras, ofereceu na segunda-feira (29), 623 vagas para os moradores da Cidade, com oportunidades para diversos níveis de escolaridade.
Entre as vagas de trabalho oferecidas, há duas para ajudante de sushiman, três para atendente de loja, quatro para auxiliar de movimentação de carga, quatro para cabeleireiro, cinco para corretor de imóveis, dez para cozinheiro marítimo, uma para enfermeiro de trabalho, duas para fonoaudióloga, duas para jardineiro e quatro para mecânico de refrigeração.
No Banco de Empregos, também são ofertadas cinco oportunidades para motorista de carreta, uma para orçamentista, quatro para pedreiro, três para porteiro, duas para planejador de manutenção, 40 vagas para soldador TIG/ER/MIG/AT (onshore), duas para vende-
dor externo (cursos) e uma para vendedor interno (loja de tintas).
As posições são atualizadas diariamente e podem ser consultadas por meio do Portal da Prefeitura de Rio das Ostras, no link https:// www.riodasostras.rj.gov.br/
bancodeempregos/UBE_cidadao.html.
POLOS DE ATENDIMENTO – Os interessados devem procurar um dos polos de atendimento de segunda a sexta, sempre das 8h às 17h, na sede da Secretaria de Desenvolvimento
Econômico e Turismo, na Extensão do Bosque (Praça Prefeito Cláudio Ribeiro, s/ nº), ou no Centro de Cidadania (Rua das Casuarinas, 595, no Âncora).
Também é possível se informar pelo telefone (22) 2771-6413.
Nos demais casos, o reembolso de tais quantias, aos que assim quiserem exercer o seu direito, pelo que se faz devida tal quantia desde o cancelamento injustificado, sendo, em ambos os casos, incidente atualização monetária, juros legais e demais acréscimos legais e/ou contratuais porventura existentes, sob pena de pagamento de R$ 50 mil de multa por ocorrência.
Ainda realizar o reembolso dos valores pagos pelos consumidores que adquiriram pacotes turísticos entre 31/12/2021 e 04/07/2022 (inclusive), na forma do disposto no art. 2º da lei nº14.046/20, com a modificação operada pela lei nº 14.186/21, até 31/12/2022, eis que inaplicável o inciso II do mesmo § 6º, com a redação dada pela lei nº 14.390/22, aos que adquiriram os ditos pacotes naquele período, tudo, porém, condicionado à existência de situação de emergência sanitária que tenha implicado no cancelamento dos serviços correlatos, situação esta que cessou a partir de 22/05/2022, por força da PORTARIA GM/ MS nº 913/22, pelo que se deve, a partir desta data, devolver todos os valores pagos pelos consumidores que assim o quiserem, devendo as quantias serem atualizadas, com a incidência de juros legais e demais acréscimos legais e contratuais porventura existentes, sob pena de pagamento de R$ 50 mil de multa por ocorrência.
Também realizar o reembolso dos valores pagos pelos consumidores que adquiriram pacotes turísticos a partir de 22/05/2022, na forma do art. 35, III do CDC, se assim o desejarem, desde que o cancelamento do serviço não tenha se dado por culpa sua ou fato a eles atribuível, exceto prova expressa de que o cancelamento se deu por fato decorrente de surto pandêmico de COVID-19, ainda persistente em alguma parte do planeta ou do país, quando se aplicará o disposto no inciso II, do § 6º, do art. 2º da lei nº 14.046/20, instituído pela lei nº 14.390/22, sob pena de pagamento de R$ 50 mil de multa por ocorrência.
Aponta o MPRJ que o HURB somente deve valer-se do disposto no art. 2º, § 6º, II da lei nº 14.046/20, com a modificação operada pela lei nº 14.390/22, qual seja, a devolução para os que com ele contrataram a partir da sua entrada em vigor, qual seja, 05 de julho de 2022, acaso comprovado que o cancelamento dos pacotes turísticos e/ou de viagem, a partir de então, se deu por força exclusivamente de surtos de COVID-19, seja dentro, seja fora do país, sem o que se fará devida a devolução da quantia paga na forma do art. 35, III da lei nº 8.078/90, não excluídas as demais faculdades do art. 35, incisos I e II da mesma lei, estipulando-se como pena pecuniária o pagamento de multa diária de R$ 50 mil por cada infração verificada. Por fim, requer o MPRJ que o HURB somente poderá proceder a novos adiamentos do reembolso dos valores pagos por pacotes de turismo ou viagens determinados por novas modificações operadas na lei nº 14.046/20 ou por quaisquer outras leis a partir da sua entrada em vigor, vedada qualquer retroação dos efeitos destas leis ou modificações realizadas ou contratos de pacotes turísticos ou de viagens firmados em período anterior à sua entrada em vigor. E que o HURB deve cumprir com o ofertado no mercado de consumo observando as datas opcionais fornecidas pelo consumidor de modo que seja efetivamente cumprido o serviço turístico contratado, bem como a fornecer as informações inerentes a tal serviço, também estipulando-se como pena pecuniária o pagamento de multa diária de R$ 50 mil por cada infração verificada. Processo nº 0871577-31.2022.8.19.0001
A cidade com o terceiro melhor clima do mundo e com um charme de tirar o fôlego, traz como seu cartão postal o Lago de Javary, local que remete a qualquer turista a mais bela sensação: a paz. Situada a 618 metros acima do mar, a cidade do interior tem em seus requisitos charme, belezas naturais, temperatura amena e segurança.

Para os amantes natureza, cachoeiras e lagos são os pontos preferidos. As trilhas e os esportes também são destaque na cidade.
Miguel Pereira carrega muita cultura, história, pontos turísticos e um clima perfeito para bons passeios e muito descanso.
Comida caseira, hotéis, pousadas e resorts estão espalhados por todos os melhores locais de Miguel Pereira, que contam com uma média de 3600 leitos da rede hoteleira.
O fácil acesso aos grandes centros, é outra opção favorável da cidade. Miguel Pereira fica estrategicamente localizada próxima as importantes vias de acesso.
Os meses de abril e setembro são ideais para roteiros turísticos, a temperatura amena e agradável permite que o visitante explore as belezas naturais. Entre os meses de dezembro e março, Miguel Pereira fica mais movimentada, por conta do período de férias e festas, das quais a cidade é conhecida pelos tradicionais blocos de rua, com festividades seguras e para toda família.
LAGO DE JAVARY

O lago Javary se encontra no bairro Barão de Javary no segundo distrito do município de Miguel Pereira. Um dos cartões postais da cidade e seu acesso é facilitado por estar a menos de três quilômetros do centro da cidade ficando com suas vias parcialmente fechadas aos finais de semana e feriados.
VIADUTO ENG. PAULO DE FRONTIN
O Viaduto Paulo de Frontin é um viaduto ferroviário localizado próximo à estrada de Vera Cruz, no município fluminense de Miguel Pereira. O viaduto possui estrutura metálica treliçada, formando um grande arco sobre o rio Santana. É considerado o único viaduto em ferro e em curva no mundo. Atualmente é utilizado para práticas esportivas.
MONUMENTO NATURAL GRUTA DOS ESCRAVOS
A Gruta dos Escravos foi construída por escravos, no século XVIII, na Serra de Miguel Pereira, em homenagem à Nossa Senhora da Penna. Além da capela, a gruta possui várias pedras que foram talhadas pelos escravos.
CAMINHO DO IMPERADOR
O Caminho do Imperador foi a primeira via para pedestres e animais construída no início do século XVIII ligando o Rio de Janeiro a Minas Gerais. O Imperador passava pela região, principalmente no início do ciclo do ouro, quando viajava a Minas.
MUSEU FRANCISCO ALVES

Miguel Pereira é muito procurado por veranistas devido ao seu clima ameno, considerado o 3º melhor do mundo. O cantor Francisco Alves se refugiou na cidade em busca de tranquilidade e deste clima agradável. Discos, partituras, microfones, roupas, instrumentos musicais e ampla iconografia do artista, reunidos no Museu Francisco Alves, contam a trajetória do cantor, que costumava frequentar Miguel Pereira.
CACHOEIRAS DE VERA
CRUZ
As cachoeiras de Vera Cruz são os melhores locais para conhecer a natureza e se refrescar em Miguel Pereira. Localizadas no bairro Vera Cruz, os locais são de fácil acesso pela estrada de terra em meio a mata atlântica, e por isso encanta a todos que passam por lá. Com uma linda paisagem, as cachoeiras são algumas das melhores do Rio de Janeiro.
RAMPA DE VÔO LIVRE
Para quem gosta de voar de parapente, Miguel Pereira possui rampa de voo com característica peculiar, pois se voa para dentro da cidade. O visual é fantástico
tanto para o piloto quanto para os freqüentadores dos bares, restaurantes e comércio em geral, pois a população tem o privilégio de observar os parapentes sobrevoando o município desde a decolagem.
RESTAURANTES
Adega do Abel
Rua Izolina Ayrão Portella, 520 Governador Portela, Miguel Pereira - RJ (24) 2484-5321
Agito’s Bar Rua Dr Luiz Pinto 556, Centro, Miguel Pereira - RJ (24) 98106-4867 / (24) 2484-7563
Bistrô Coisa Nossa
Rua Bonifácio Portela, 346, Loja 3 Centro, Miguel Pereira - RJ (24) 99848-1145
Bom Clima
Rua Cipriano Gonçalves, s/nº Centro, Miguel Pereira - RJ (24) 2484-2844
Casa Nethuria Kombucheria Bistrô
Rua dos Coqueiros, 123A, Retiro das Palmeiras, Miguel Pereira - RJ
(21) 98815-7530
Cabana do Pajé Rua Algecira Alarcão Ferreira, 33 Centro, Miguel Pereira - RJ (24) 2482-2669
Comilância Rua Algecira Alarcão Ferreira, 39 Centro, Miguel Pereira - RJ (24) 2484-5085
Contém Afeto Rua Zélia, 12 Centro, Miguel Pereira - RJ
(24) 2090-1450 / (21) 99956-1366
Dika Perfeita
Shopping Florescer Centro, Miguel Pereira - RJ (24) 2484-1650
Dom Cláudius RJ 125, 29783
Conrado, Miguel Pereira - RJ (24) 98173-3307 / (24) 98137-0779
Garagem
Avenida Marechal Rondon, 423, Loja 1 Plante Café, Miguel Pereira - RJ (24) 98180-3319
Las Chicas
Rua Dr. Joaquim Nicolau, 961 Praça da Ponte, Miguel PereiraRJ (24) 98156-3027 / (24) 2484-4252
Lé Velo Montagne Av. Marechal Rondon, 500 Barão de Javary, Miguel PereiraRJ (24) 2484-4811
Maria Fumaça
Rua Maria José, 36, Calçadão do Viô Centro, Miguel Pereira - RJ (24) 2483-0050
Marine Restaurante – Costa Del Mar
Rua Comandante Paulo Emílio, Lago de Javary Barão de Javary, Miguel PereiraRJ (24) 99612-1366
Mexido Mineiro – Restaurante e
Petiscaria Avenida Marechal Rondon, 425 Plante Café, Miguel Pereira - RJ (24) 98123-2939
Panela Velha
Rua Engenheiro Masô, 50, Vila Suissa, Miguel Pereira - RJ (24) 99322-7116
Princesa do Nilo Av. Da Paz, 110 Centro, Miguel Pereira - RJ (24) 98111-8083 / (24) 2484-2526
Refúgio do Vale
Rua Cândido Coelho de Souza, 13 Vera Cruz, Miguel Pereira - RJ (21) 99353-6507
Relíquia Restaurante Av. Roberto Silveira, 251 Centro, Miguel Pereira - RJ (24) 2090-3057
Restaurante Secreto Casa de Randufo Reservas pelo telefone (24) 981298550
Instagram: @casaderandufo
Sanjão Estrada da Piedade, 1502 Vera Cruz, Miguel Pereira - RJ (24) 98120-0704
Saudável Gourmet Av. Presidente John Kennedy, 123, Loja 5 Centro, Miguel Pereira - RJ (24) 99292-6681
Solar Azul Restaurante Estrada Manoel Guilherme da Silva, 3367 São José das Rolinhas, Miguel Pereira - RJ (24) 99254-3603
Cozinha Mediterrânea sob o comando do Cheff Edgar Fernandes
Summer Garden
Rua Bruno Lucci, 909 Summervile, Miguel Pereira, RJ (24) 2484-1814
Taberna do Barão
Rua General Ferreira do Amaral, 104 -178 Centro, Miguel Pereira - RJ (24) 2483-6570
Takemoto Sushi
Rua Machado Bitencourt, 343 Centro, Miguel Pereira - RJ
(24) 98155-4100
ZuHause
Av. Marechal Rondon, 940 Barão de Javary, Miguel PereiraRJ (21) 3900-5161
PIZZARIAS
Hummm! Pizzas Miguel Pereira
Av. Roberto Silveira, 593, Loja 102 Centro, Miguel Pereira - RJ (24) 98116-7089
Macedônia Pizzaria
R. Machado Bittencourt, 180 Centro – Miguel Pereira - RJ (24) 98105-6336
Rainha das Pizzas
Rua Dr. Joaquim Nicolau, 961 Praça da Ponte, Miguel PereiraRJ (24) 98156-3027 / (24) 2484-4252
PADARIAS, CAFETERIAS E SORVETERIAS
Armazém do Pão – Padaria
Avenida Roberto Silveira, 515 Centro, Miguel Pereira - RJ (24) 2090-1960
Armazém Estiva – Produtos Naturais Av. Roberto Silveira, 80 Centro, Miguel Pereira - RJ (24) 2484-6115
Café Bistrô
Estrada Miguel Pereira, 1178 Barão de Javary, Miguel PereiraRJ (24) 99909-3198
Cheiro de Mato Café
Rua Maria José, 101, Loja 02 Centro, Miguel Pereira - RJ (24) 2484-2980
Chocolates Bebel
Rua Geraldino Fraga, 309 Alegria, Miguel Pereira - RJ (24) 98117-9220
Doces Carmem
Rua Dr. Pedro Saullo, 70 Retiro das Palmeiras, Miguel Pereira - RJ (24) 2484-2933
Empório Estiva
Rua Áurea Pinheiro, 119 Centro, Miguel Pereira - RJ (24) 2484-8336
Delicatessen, café, produtos naturais e presentes
Padaria do Angú
Calçadão do Viô
Centro, Miguel Pereira - RJ (24) 2484-4759
Sol & Neve Sorveteria e Açaiteria
Rua Maria José, 74 Centro, Miguel Pereira - RJ (24) 98146-6274
Terra dos Chocolates
Rua Coronel Júlio Pita, 52 Centro, Miguel Pereira - RJ (21) 98089-4006
CHOPERIAS, BARES E PUBS
NOTURNOS
Chopinho da Serra Av. Roberto Silveira, 79 Centro, Miguel Pereira - RJ (24) 2484-2547
Caminho di Casa Choperia e Petiscaria Rua Machado Bittencourt, 1157 Retiro das Palmeiras, Miguel Pereira - RJ (24) 98144-3398
LANCHONETES E FAST FOODS
Bob’s Miguel Pereira Avenida César Lattes, 395 Parque Guararapes, Miguel Pereira - RJ (24) 2090-3852
Casa das Delícias Praça João XXIII
Centro, Miguel Pereira - RJ (24) 98109-2309 / (24) 2484-7880
Avalanche Av Presidente John Kennedy, 56 Centro, Miguel Pereira - RJ (24) 98156-1456 / (24) 2484-7931
Bravero Av. Marechal Rondon, 451 Plante Café, Miguel Pereira - RJ (24) 98111-9070
Mr. Paul Burgers
Rua Machado Bitencourt, 1157 Centro, Miguel Pereira - RJ (24) 98105-1058
Barbacue BNQ Av. Cesár Lattes, 349 Centro, Miguel Pereira - RJ (24)98105-2613
RUA COBERTA – POLO GASTRONÔMICO
R. Gen. Ferreira do Amaral Centro, Miguel Pereira – RJ Um complexo turístico, cultural e gastronômico com as seguintes lojas: Lugano Chocolates, Domino’s Pizza, Chez Michou Creperia, Spoleto Cozinha Italiana, TRextaurante and Burgues, Luigui Sorvetes, Kimi Sushibar, Bistrô do Lago.

7 - Variedades Tribuna dos Municípios Terça-feira, 30 de Maio de 2023
Como medida concreta para marcar o Dia Mundial Contra o Trabalho Infantil de 2023 (12 de junho), a Justiça do Trabalho vai promover atéo dia 2 de junho, um mutirão de julgamentos de processos que versem sobre trabalho infantil e aprendizagem profissional. A pauta temática é uma das ações da Justiça do Trabalho, em parceria com o Ministério Público do Trabalho (MPT), em alusão ao Dia Mundial Contra o Trabalho Infantil (12 de junho) e que terá ações relacionados ao tema durante todo o mês de junho.

Convidados ouvidos pela Comissão de Direitos Humanos (CDH) na segunda-feira (29) defenderam a continuidade da luta pela obrigatoriedade de salários iguais entre homens e mulheres. Os debatedores pediram também agilidade de discussão, pelo Senado, do PL 1.085/2023, que prevê multa de dez vezes o maior salário pago por uma empresa em caso de descumprimento da igualdade salarial. Em caso de reincidência, a multa deverá ser elevada em 100%. Já aprovado pela Câmara, o texto é de iniciativa do Poder Executivo e tramita em regime de urgência.

SanMon Rapidinhas
Envie suas críticas, sugestões e reclamações para o e-mail tribunadosmunicipios@ gmail.com e veja-as publicadas na próxima edição.
A Segunda Turma do Supremo Tribunal Federal anulou uma condenação do ex-deputado federal Eduardo Cunha na operação Lava Jato. Ele havia sido sentenciado pela Justiça Federal do Paraná a quase 16 anos de prisão, por corrupção passiva e lavagem de dinheiro. A Corte determinou ainda o envio da investigação para a Justiça Eleitoral. Caberá ao novo juiz decidir se restabelece ou não a condenação de Cunha, além da validade das provas, ou se o caso será retomado da estaca zero.

• 3 colheres (sopa) de azeite
• 1kg de ossobuco
• 2 dentes de alho picados
• 1 cebola picada
• 1 xícara (café) de molho de soja (shoyu)
• 1 cubo de caldo de carne

• 3 xícaras (chá) de água
• 2 batatas em cubos
• 2 cenouras em cubos
• 200g de vagem picada
• Sal e cheiro-verde picado a gosto
Modo de preparo:
Em uma panela de pressão, em fogo médio, aqueça o azeite.
Senhor Deus, que sempre combateis por nós, concedei-nos por intercessão de Santa Joana d’Arc expulsar de nossas vidas a invasão das tentações e pecados, que de Vós nos afastam, e pretendem nos dominar com falsas promessas de bens deturpados; pois só Vos ouvindo, e obedecendo à Palavra que ensinas é que restauraremos Vosso reinado na alma e poderemos participar da Vossa corte celestial. Por Nosso Senhor Jesus Cristo, Vosso Filho, e Nossa Senhora. Amém.

Observe o que se passa na vida: quando você necessita de alimento, é só você que pode comer. Ninguém pode fazêlo por você. Assim, também, ninguém pode curálo. Você é a única pessoa capaz de curarse, de fazer seu corpo revigorarse e liberarse das enfermidades. Emita pensamentos positivos de saúde e expulse de seu organismo todas as moléstias.
Cientistas usaram inteligência artificial (IA) para desenvolver um novo antibiótico capaz de matar uma espécie mortal de superbactéria. A tecnologia ajudou a filtrar uma lista de milhares de compostos químicos em potencial, reduzindo-os a apenas alguns que poderiam ser testados em laboratório. O resultado foi um potente antibiótico experimental chamado abaucina, que vai precisar passar por mais testes antes de ser usado. Os pesquisadores, do Canadá e dos EUA, dizem que a IA tem o poder de acelerar consideravelmente a descoberta de novos medicamentos. É o exemplo mais recente de como ferramentas de IA podem ser uma força revolucionária na ciência e na medicina.
MARIE FREDRIKSSON COMPLETARIA 65 ANOS
A artista nasceu em Össjö (Suécia) no dia 30 de maio de 1958.
Origem
Nascida no berço de uma família com cinco filhos em Össjö, na Suécia, Marie foi a caçula da casa e desde a mais tenra infância demonstrou interesse por música.
Aos 17 anos entrou em uma escola de música da região e passou a fazer apresentações pontuais no teatro da cidade.
Carreira
Quando começou a namorar Stefans, criou uma banda chamada chamada Strul que fez uma série de participações em festivais locais. Com o término da relação, a banda chegou ao fim.
Com o novo namorado, Martin Sternhuvsvud,

fundaram a banda MaMas, que também teve vida curta.
Em 1984 Marie resolveu investir em uma carreira solo e emplacou seu primeiro single intitulado Ännu Doftar Kärlek. Rapidamente ela se tornou um nome de destaque da música feminina sueca.
Algum tempo mais tarde, Marie travou amizade com Per Gessle, com quem veio a formar um grupo (Roxette). Apesar de se apresentar em conjunto, Marie seguiu com a carreira solo e em 2013 lançou o álbum Now, com o qual fez uma turnê.
Roxette Em 1986 os Roxette emplacaram o primeiro hit (Neverending Love) e lançaram o primeiro álbum (Pearls of passion).
O conjunto criou clássicos da música das décadas de 80 e 90 como Listen to your heart, It must have been love, How do you do!, Sleeping
in my car, Dangerous, Fading like a flower e Dressed for success.
A banda chegou a se apresentar em 2010 no Palácio Real de Estocolmo durante o casamento da princesa Vitória da Suécia com Daniel Wes-
tling. Os Roxette alcançaram a impressionante marca de mais de 75 milhões de discos vendidos.

Artes plásticas Além de cantar, a compositora também
produzia uma série de desenhos a carvão que funcionavam como uma espécie de terapia.
Marido e filhos Marie foi casada com Mikael Bolyos, com quem compunha. O ca -
Morte
Durante 17 anos Marie Fredriksson lutou contra o câncer, que foi pela primeira vez diagnosticado em 2002.
Afastada do palco devido ao tratamento, Marie retomou a agenda em 2009 e permaneceu na ativa até 2016, quando foi obrigada a se dedicar somente à saúde.
A artista faleceu aos 61 anos vítima de um tumor no cérebro. A respeito da morte de Marie, Per Gessle, seu companheiro no Roxette, divulgou nota dizendo:
Não tanto tempo atrás, passávamos dias e noites em meu pequeno apartamento compartilhando sonhos impossíveis. Estou honrado de ter compartilhado seu talento e generosidade. As coisas nunca mais serão as mesmas.
mento Participativo (POP) de forma on-line até 30 de junho. Para votar, basta acessar o link https://www.riodasostras. rj.gov.br/poponline/ CONSELHO MUNICIPAL - Órgão consultivo da Administração, o Conselho Municipal de Planejamento e Orçamento Participativo – CMPOP é composto por membros da sociedade civil e do Poder Público. Instituído pela Lei nº 780/2003 e atualizado pela Lei 2159 e 2163/2018, o CMPOP sugere a inclusão na Legisla-
ção Municipal de demandas prioritárias apontadas pela população.
ORÇAMENTO PARTICIPATIVO – Instrumento de mobilização popular, o Orçamento Participativo é um mecanismo democrático já que, por meio dele, a população discute e decide sobre politicas e orçamentos públicos. Responsável por fazer o levantamento das necessidades de cada setor, o OP promove a discussão das prioridades de acordo com o orçamento do Município.
CALENDÁRIO DAS AUDIÊNCIAS SETORIAIS 2023


Rio das Ostras prossegue com as Audiências Públicas que possibilitam aos moradores indicar prioridades de investimentos públicos para 2024. As reuniões são pro-
movidas pela Prefeitura, por intermédio da Secretaria de Gestão Pública, e o Conselho Municipal de Planejamento e Orçamento Participativo – CMPOP. O próximo
encontro, para o Setor H (H (Village e Residencial Praia Âncora), será nesta terça, dia 30, das 18h30 às 21h, na Escola Municipal Simar Machado Sodré (Avenida das



Flores, s/nº – Âncora).
VOTAÇÃO ON-LINEAlém de participar das reuniões setoriais, a população pode escolher as prioridades para o Planejamento e Orça-
A Secretaria de Saúde de Rio das Ostras promoveu na quinta-feira (25), uma capacitação em primeiros socorros para a formação de agentes comunitários de saúde e agentes de combate às endemias. O curso técnico tem como objetivo capacitar as duas categorias profissionais a fim de melhorar os indicadores de saúde, qualificar com resolutividade os serviços da Atenção Pri-
mária e prestar um atendimento melhor à população, em casos de extrema urgência.

A capacitação foi organizada em um modelo híbrido de ensino, com atividades educacionais desenvolvidas na modalidade à distância e atividades presenciais, realizadas no ambiente de trabalho, em que os cenários de produção de cuidado são tam
bém cenários de produção pedagógica na formação dos profissionais.


O curso ministrado compõe a grade curricular de formação técnica dessa classe de trabalhadores.

A Portaria do Ministério da Saúde nº 3.241, de 7 de dezembro de 2020, instituiu o “Programa Saúde com Agente”, em parceria com o Conselho Nacional de Secretarias Municipais de Saú-
de e a Universidade Federal do Rio Grande do Sul. Segundo informa Fernanda Peres, diretora do Departamento de Saúde da Família, as preceptoras da fase presencial do curso são servidoras de diversas áreas
lotadas na Secretaria de Saúde que estão engajadas na formação dos ACS E ACE que estão no acompanhamento das famílias de cada micro área.
“Estamos imbuídos junto com Departamento de Edu-
cação Permanente fomentando várias temáticas de qualificação dos profissionais inseridos na Atenção Primária à Saúde, tudo para oferecer mais qualidade nos atendimentos aos munícipes”, contou.
Alunos da Escola Fazenda da Praia Municipalizada foram protagonistas no processo de aprendizagem As formas de medir o tempo ao longo da história foram abordadas de forma inovadora e participativa na Escola Fazenda da Praia Municipalizada, no bairro Mar do Norte. Os alunos da turma 501 desenvolveram o tema por meio da metodologia “sala de aula invertida”, em que o estudante é incentivado a ser protagonista de seu processo de aprendizagem. A iniciativa resultou em exposição dos trabalhos e envolvimento das equipes e demais alunos.
A ideia de realizar a “sala de aula invertida” surgiu após os alunos demonstrarem curiosidade sobre o assunto. “Por ser uma turma participativa e que ama trabalhar com essa metodologia, colocamos as mãos à obra. Os alunos trouxeram informações além do esperado, como Calendário Pataxós, Relógio do Sol, Relógio da Vela e a Ampulheta. E para valorizar esses trabalhos, realizamos uma exposição que teve a visitação da equipe
pedagógica e dos demais alunos. Temos que valorizar e incentivar nossos alunos, pois a educação é o caminho certo”, contou a professora Rita de Cássia.
A metodologia de sala de aula invertida foi uma das reflexões trazidas pelo curso “Descomplicando a Matemática”, oferecido aos profissionais da Rede Pública de Ensino de Rio das Ostras. “Esta foi uma experiência que deu certo. As crianças deram um show com a mediação da professora para que a pesquisa ficasse melhor distribuída”, disse a coordenadora de Anos Iniciais, Ivanise Daniel, que visitou a exposição.

SALA DE AULA INVERTIDA
- o foco da metodologia é fazer o estudante adquirir conhecimentos de forma mais autônoma. Assim, o professor tem o papel de orientar o roteiro de estudos do aluno, conduzir discussões sobre os temas em sala de aula, propor a realização de projetos e atividades relacionadas e trazer pontos complementares para o assunto. Na sala de aula invertida, o estudante é estimulado a ser protagonista e o professor é orientador no processo de aprendizagem do estudante.
CURSOS PARA PROFESSORES – Descomplicando a Matemática e Descomplicando a Língua Portuguesa são cursos voltados para os professores do 5º ano. As inscrições para as qualificações presenciais ainda estão disponíveis no portal da Educação, na Plataforma da Formação Continuada. O objetivo dos cursos é potencializar o processo de ensino-aprendizagem e estimular o compartilhamento de práticas e saberes entre os docentes. São realizadas oficinas para o desenvolvimento de competências e habilidades que apresentaram menos êxito na Avaliação Diagnóstica do Sistema de Avaliação Educacional de Rio das Ostras – Saero. Também serão abordados os descritores contemplados nas Matrizes de Referência do Sistema Nacional de Avaliação da Educação Básica – Saeb. Ambas as formações acontecem na modalidade presencial, no Colégio Municipal Professora América Abdalla, às terças-feiras, das 18h às 21h, conforme os cronogramas disponibilizados.